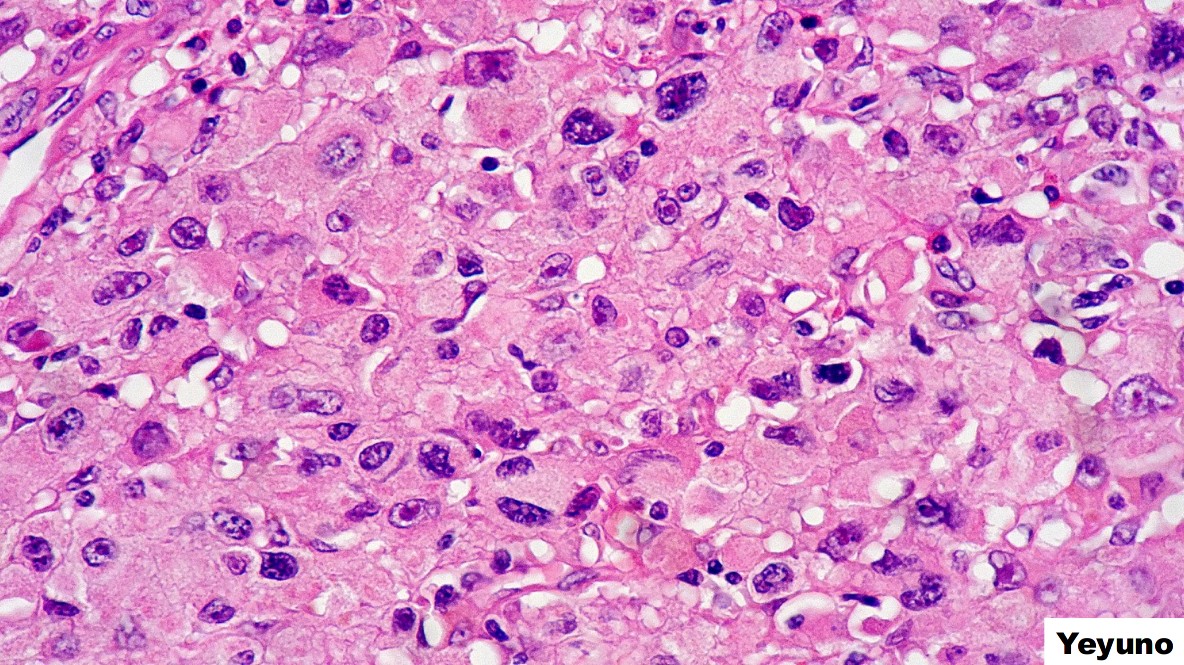
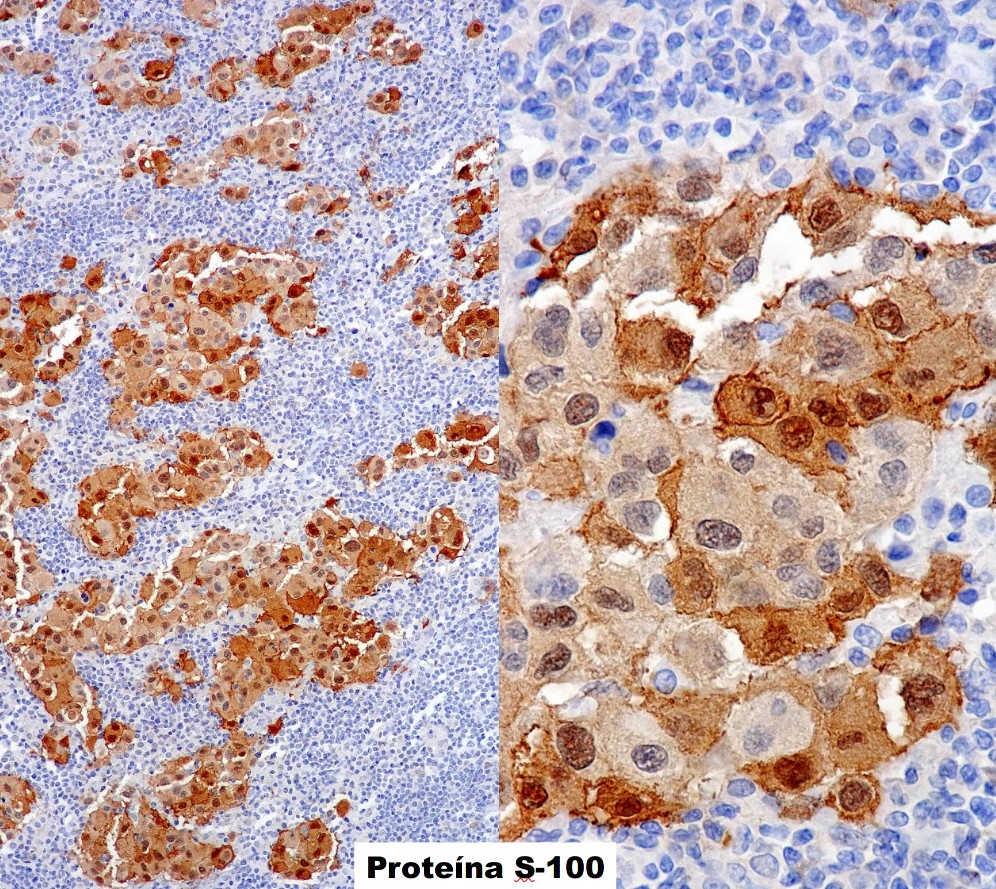
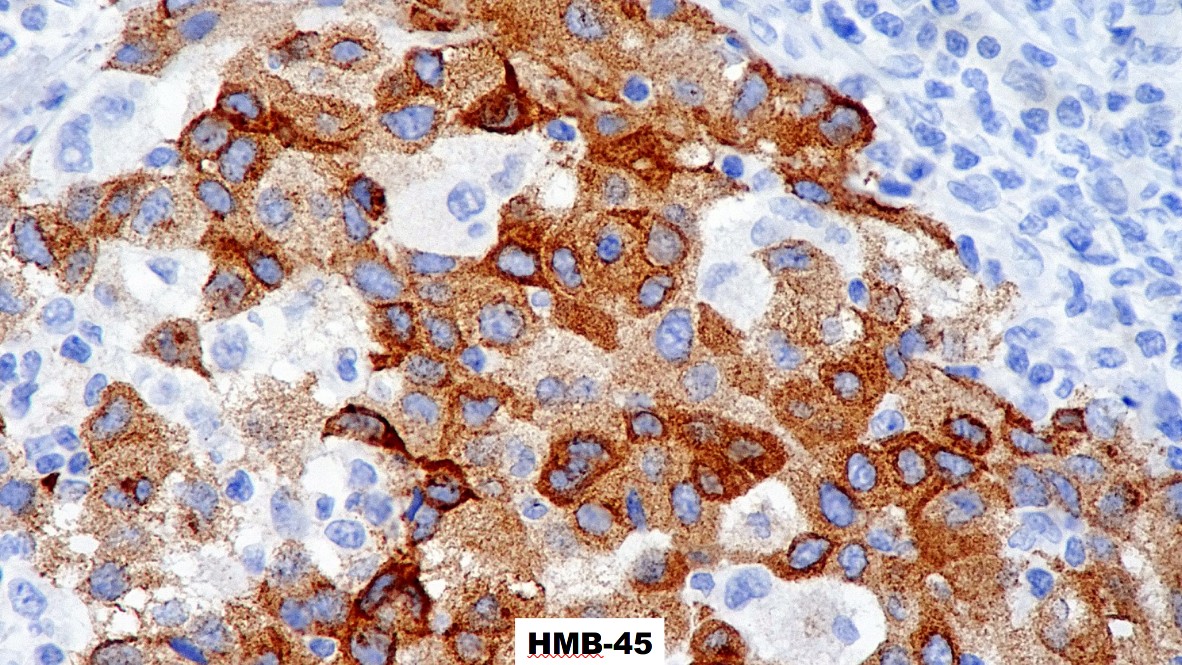

COORDINA: DR. MARIO MURGUIA PEREZ.
CASO CORTESÍA DR. SAULO MENDOZA RAMÍREZ – HOSPITAL GENERAL DE MÉXICO “DR. EDUARDO LICEAGA”
Información clínica:
Mujer de 58 años
Originaria y residente: Ciudad de México
Ocupación: médico
Religión: católica
AHF: abuela paterna con carcinoma de laringe
APP: colecistectomía hace 28 años por colelitiasis y resección de quiste de baker a los 8 años de edad.
PA: Inició su padecimiento en el 2015 con adenopatía en región cervical derecha, sin otra sintomatología. Se realizó USG externo con reporte de adenopatía de 1.5 x 1.4 x 1.1 cm, y se realizó biopsia excisional.

PREGUNTA 1
Acorde a tu diagnóstico por H-E en ganglio linfático, ¿Qué batería de inmunohistoquímica pedirías con esa morfología?
A) CK7, CK20, P63, TTF-1, GCDFP-15
B) CKAE1-AE3, S100, CD45, VIMENTINA
C) CD45, CD3, CD20, ALK, CD68
PREGUNTA 2
El tumor en yeyuno presenta una morfología epitelioide con crecimiento submucoso, por los hallazgos microscópicos se debe pedir lo siguiente:
A) MLH-1, MSH-2, MSH-6, PMS-2, P53
B) CD117, DOG-1, CD34, S100 Y ACTINA
C) CD45, CD20, CD3, VEB, ALK, CD30
PREGUNTA 3
El tumor de yeyuno sólo expresa s100, por lo que harías lo siguiente:
A) El diagnóstico es un GIST epitelioide.
B) Ampliaría batería de inmunohistoquímica para descartar un tumor histiocítico o de células dendríticas
C) Buscaría marcadores melanocíticos y agregaría BRAF.